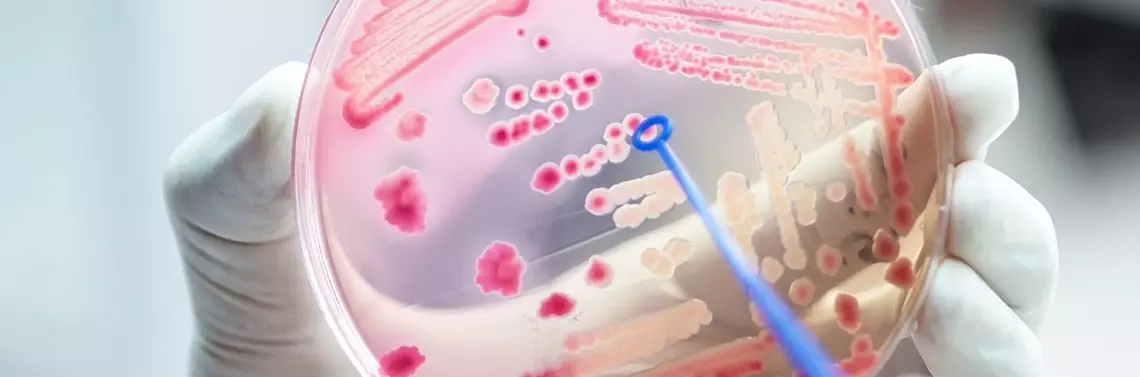

Sepsa jest jedną z głównych przyczyn śmiertelności oraz ciężkiego stanu pacjentów na świecie. Wskaźnik śmiertelności dla populacji ogólnej wynosi 28,6% [1].
Sepsa u pacjentek położniczych, którą definiuje się jako sepsę, która wystąpiła podczas ciąży lub po porodzie, jest odpowiedzialna za 10,7% globalnej śmiertelności matek [2]. W Stanach Zjednoczonych sepsa jest czwartą co do częstości występowania przyczyną śmiertelności matczynej. Występuje w 0,04% porodów, jednak odpowiada aż za 23% przypadków śmiertelności okołoporodowej [3]. Najnowsze dane wskazują, że można zapobiec 63% śmierci u kobiet ciężarnych spowodowanych sepsą [4]. Z tego powodu wczesne rozpoznanie, prawidłowa ocena oraz odpowiednie leczenie sepsy u pacjentek w ciąży są niezbędne, aby zredukować zachorowalność i śmiertelność wśród tej populacji.
Diagnozowanie sepsy w ciąży pozostaje wyzwaniem, ponieważ fizjologiczne zmiany w organizmie kobiety w ciąży mogą maskować niektóre z objawów. Ponadto etiologia sepsy ciężarnych różni się od przyczyn w populacji ogólnej. Dodatkowo optymalne leczenie wymaga rozważenia potrzeb zarówno matki, jak i płodu.
REKLAMA
Definicje sepsy i wstrząsu septycznego
W 2016 r. podczas III Międzynarodowej Konferencji (Sepsis-3) opublikowano nowe definicje sepsy i wstrząsu septycznego. Zrezygnowano wtedy z pojęć SIRS (zespołu ogólnoustrojowej reakcji zapalnej) oraz „ciężkiej sepsy”, która obecnie odpowiada definicji sepsy, czyli zagrażającej życiu dysfunkcji narządowej, która jest spowodowana zaburzoną regulacją odpowiedzi ustroju na zakażenie. Odpowiedź ta powoduje uszkodzenie tkanek i narządów. Wstrząs septyczny natomiast jest definiowany jako sepsa, w której zaburzenia ze strony układu krążenia, zaburzenia metaboliczne i na poziomie komórkowym są tak głębokie, że znacząco zwiększają śmiertelność. Wstrząs septyczny rozpoznaje się, jeśli pomimo właściwej resuscytacji płynowej stężenie mleczanu w surowicy wynosi > 2 mmol/l (18 mg/dl) oraz występuje hipotensja wymagająca zastosowania leków obkurczających naczynia krwionośne do podwyższenia średniego ciśnienia tętniczego ≥ 65 mm Hg.
World Health Organization definiuje sepsę matczyną jako zagrażającą życiu dysfunkcję narządową spowodowaną zakażeniem podczas ciąży, porodu, po poronieniu/aborcji lub w trakcie okresu poporodowego.
Czynniki ryzyka oraz etiologia sepsy ciężarnych
Położnicy mają szczęście – ich pacjentki są generalnie młode i zdrowe. Jednak sepsa nie występuje rzadko. W krajach rozwiniętych jest najczęściej wynikiem infekcji okołoporodowych w przeci...
Pozostałe 90% treści dostępne jest tylko dla Prenumeratorów
- 6 wydań czasopisma "Forum Położnictwa i Ginekologii"
- Nielimitowany dostęp do całego archiwum czasopisma
- Zniżki w konferencjach organizowanych przez redakcję
- ...i wiele więcej!

Dołącz do społeczności lekarzy, którzy stawiają na rzetelną, aktualną wiedzę!
Sięgnij po Forum Położnictwa i Ginekologii i co dwa miesiące otrzymuj praktyczne artykuły, analizy oraz narzędzia tworzone przez specjalistów z wieloletnim doświadczeniem klinicznym.